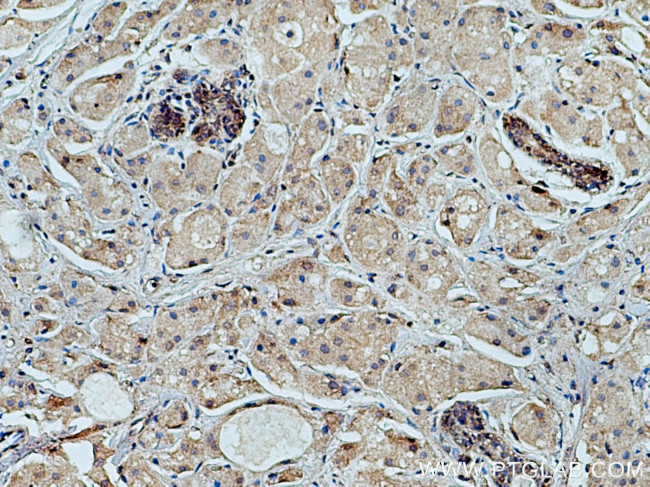
FCHSD1 Antibody in Immunohistochemistry (Paraffin) (IHC (P))

Search
Proteintech
FCHSD1 Polyclonal Antibody
{{$productOrderCtrl.translations['antibody.pdp.commerceCard.promotion.promotions']}}
{{$productOrderCtrl.translations['antibody.pdp.commerceCard.promotion.viewpromo']}}
{{$productOrderCtrl.translations['antibody.pdp.commerceCard.promotion.promocode']}}: {{promo.promoCode}} {{promo.promoTitle}} {{promo.promoDescription}}. {{$productOrderCtrl.translations['antibody.pdp.commerceCard.promotion.learnmore']}}
产品信息
23362-1-AP
种属反应
宿主/亚型
分类
类型
抗原
偶联物
形式
浓度
规格
纯化类型
保存液
内含物
保存条件
运输条件
产品详细信息
Immunogen sequence: AEVLQSVRE LSRSRKLYGQ RERVWALAQE KAADVQARLN RSDHGIFHSR TSLQKLSTKL SAQSAQYSQQ LQAARNEYLL NLVATNAHLD HYYQEELPAL LKALVSELSE HLRDPLTSLS HTELEAAEVI LEHAHRGEQT TSQVSWEQDL KLFLQEPGVF SPTPPQQFQP AGTDQVCVLE WGAEGVAGKS GLEKEVQRLT SRAARDYKIQ NHGHRVLQRL EQRRQQASER EAPSIEQRLQ EVRESIRRAQ VSQVKGAARL ALLQGAGLDV ERWLKPAMTQ AQDEVEQERR LSEARLSQRD LSPTAEDAEL SDFEECEETG ELFEEPAPQA LATRALPCPA HVVFRYQGVR MS (59-409 aa encoded by BC047016)
靶标信息
FCHSD1 gene ontology annotations related to this gene include neuromuscular synaptic transmission; regulation of actin filament polymerization.
仅用于科研。不用于诊断过程。未经明确授权不得转售。
生物信息学
蛋白别名: F-BAR and double SH3 domains protein 1; FCH and double SH3 domains protein 1; FLJ00007; nervous wreck homolog 2; NWK2; Protein nervous wreck 2
基因别名: FCHSD1; NWK2; UNQ737/PRO1431
UniProt ID: (Human) Q86WN1
Entrez Gene ID: (Human) 89848